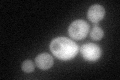
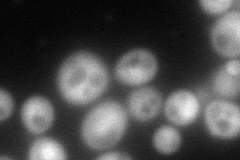
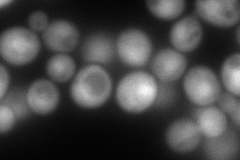
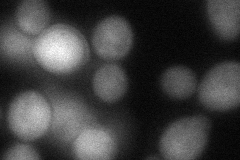
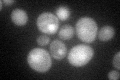

View description
Mitogen-activated protein kinase involved in osmoregulation via three independent osmosensors; mediates the recruitment and activation of RNA Pol II at Hot1p-dependent promoters; localization regulated by Ptp2p and Ptp3p
Localization:
Intensity:
Fold change:
Significance:
-
C’ GFP library in SD
cytosol68.89 -
N' NOP1pr-GFP in SD
cytosol156.402 -
N' TEF2pr-mCherry in SD
nucleus217.879 -
N' NATIVEpr-GFP in SD

cytosol63.4551 -
N' TEF2pr-VC and Cyto-VN in SD
cytosol60.1452 -
C’ GFP library in SD+DTT

cytosol81.791.18No -
C’ GFP library in SD+H2O2

cytosol70.041.01No -
C’ GFP library in Starvation Media
nucleusN/AN/AYes -
C’ GFP library on the background of Pup2-DaMP

cytosol -
C’ GFP library on the background of CCT mutant

cytosol63.98720.928685No
